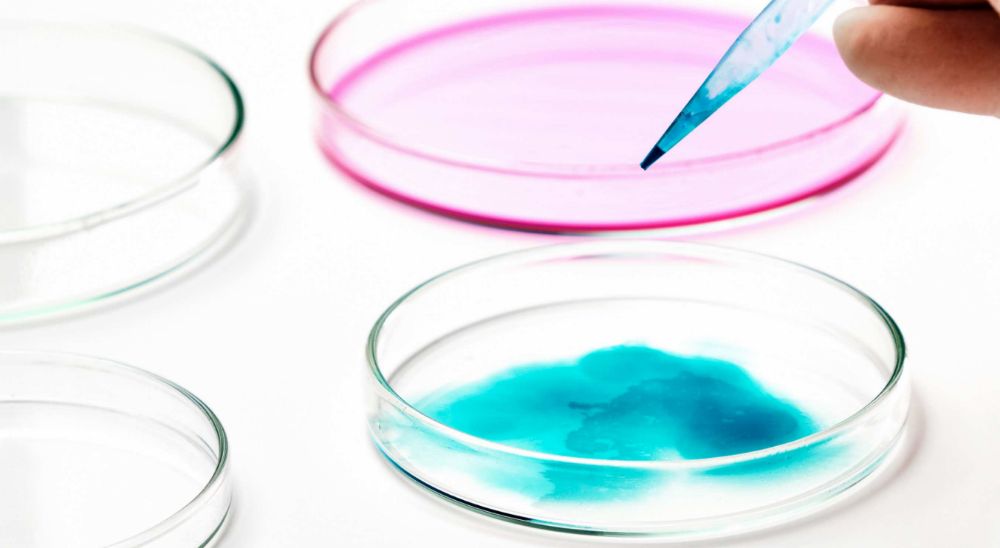
Embryo biopsy for sex selection in lebanon in Azoury IVF lebanon Clinic Embryo biopsy for sex selection in lebanon in Azoury IVF lebanon Clinic

Preimplantation Genetic Testing And Embryo Sex Selection
Preimplantation genetic testing mainly allows the couple undergoing IVF to avoid giving birth to a child carrying or suffering from a hereditary disease present in the family. A wider genetic screening can be used in case of repetitive miscarriages or repetitive IVF failures to check whether they are due to a genetic problem. PGT can also be performed to determine the sex of the embryos before pregnancy.
Embryo biopsy for PGT is performed on cleaving stage embryos (Day 3) or blastocysts (day 5). One or more cells are taken out from the embryo using a very delicate biopsy technique and sent to the genetic lab for testing.
Azoury IVF Clinic embryologists have a big experience in PGT, that is very widely used for sex selection purposes in the Mena region.